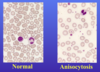
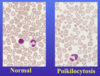
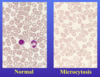
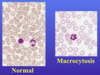
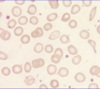
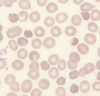
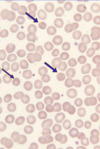
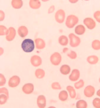
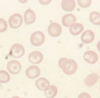
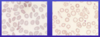
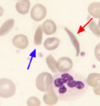
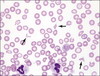

Physiology of blood cells and haematological terminology Flashcards
(46 cards)
What are all types of blood cells derived from?
Multipotent haematopoietic stem cells in the bone marrow
Describe the stem cell heirarchy.

What is an essential characteristic of stem cells and how is this achieved?
They have the ability to self-renew and produce mature progeny (i.e. differentiate)
They can divide into two cells with different characteristics:
- One is another stem cell
- One is capable of differentiating into mature progeny
Describe the normal erythroid maturation process.
- Multipotent lymphoid-myeloid stem cell
- Myeloid stem cell
- Proerythroblast
- Erythroblast (have early, intermediate and late stages)
- Erythrocyte (RBCs)
What is the process of producing RBCs called?
Erythropoeisis
What does eythropoeisis require?
Erythropoeitin (hormone)
Secreted into capillaries (bloodsteam) and results in increased bone marrow activity and RBC production
Where is erythropoeitin synthesised?
Kidney juxtatubular interstitial cells (90%)
Liver (10%)
What triggers the production of erythropoeitin?
Hypoxia
Anaemia
What is the lifespan of erythrocytes?
120 days - ultimately destroyed by phagocytic cells of spleen
What is the main function of erythrocytes?
Oxygen transport - also transports some carbon dioxide
Describe the development pathway of some of the WBCs that multipotent haematopoetic stem cells give rise to? What does this require?
Development pathway:
- Multipotent lymphoid-myeloid stem cell
- Myeloid stem cell
- Granulocyte-monocyte which gives rise to:
- Myeloblast → granulocyte (neutrophil, eosinophil, basophil)
- Monoblast → monocyte
This development process needs:
- Cytokines e.g:
- G-CSF (granulocyte colony-stimulating factor)
- M-CSF (granulocyte-macrophage colony-stimulating factor)
- GM-CSF (macrophage colony-stimulating factor)
- Various interleukins
What is the lifespan of neutrophils?
Survives 7–10 hours in the circulation before migrating to tissues
NOTE: Lifespan of WBCs refers to how long they survive in circulation if not activated - if they are activated then they will migrate into tissues
What is the main function of neutrophils?
Defence against infection
- It phagocytoses and then kills micro-organisms
What is the lifespan of eosinophils?
Less than neutrophils - i.e. spends less time in the circulation than neutrophils
What is the main function of eosinophils?
Defence against parasitic infections
What is the lifespan of basophils?
Hours - days
What is the main function of basophils?
They have a role in allergic responses
What is the lifespan of monocytes?
Several days
What is the main function of monocytes?
They migrate to tissues where they develop into macrophages and other specialized cells that have a phagocytic and scavenging function
Macrophages also store and release iron
What is the lifespan of lymphocytes?
Variable
- Lymphocytes recirculate to lymph nodes and other tissues and then back to the bloodstream
- Therefore, their intravascular life span is very variable
What is the main function of lymphocytes?
To respond to foreign invaders in the body
What is the lifespan of platelets?
10 days
What is the main function of platelets?
They have a role in primary haemostasis
- Contribute phospholipid which promotes blood coagulation
- Activated platelets express negatively charged phospholipids (e.g. phosphatidylserine) on their surfaces
- This provides a site for the assembly of enzyme substrate complexes required for certain reactions in the coagulation cascade
Define anisocytosis.
RBCs show more variation in size than is normal